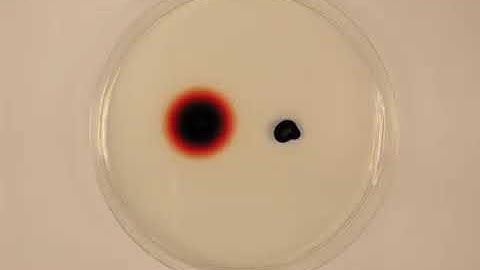
Diffusion of Dye in Agar

⬇ DOWNLOAD NOW
Kalau muncul iklan pop-up, tutup lalu klik tombol kembali
Download lagu diffusion of dye secara gratis hanya untuk keperluan promosi. Dukung artis favorit kamu dengan membeli musik original di iTunes atau platform resmi lainnya.
 Diffusion of Dye in Agar
Diffusion of Dye in Agar
 Diffusion of dye in water demo
Diffusion of dye in water demo
 Diffusion of Food Dye 2
Diffusion of Food Dye 2
 CCC Online Biology Resources - diffusion of dye in water time lapse
CCC Online Biology Resources - diffusion of dye in water time lapse
 Diffusion of Food Dye in Ice Cold Water | A Compilation of Enzo’s Diffusion Experiment
Diffusion of Food Dye in Ice Cold Water | A Compilation of Enzo’s Diffusion Experiment
 Diffusion of dye video
Diffusion of dye video
Diffusion of Dye in Agar
Diffusion of Dye in Agar
 The Effect of Temperature on Dye Diffusion
The Effect of Temperature on Dye Diffusion